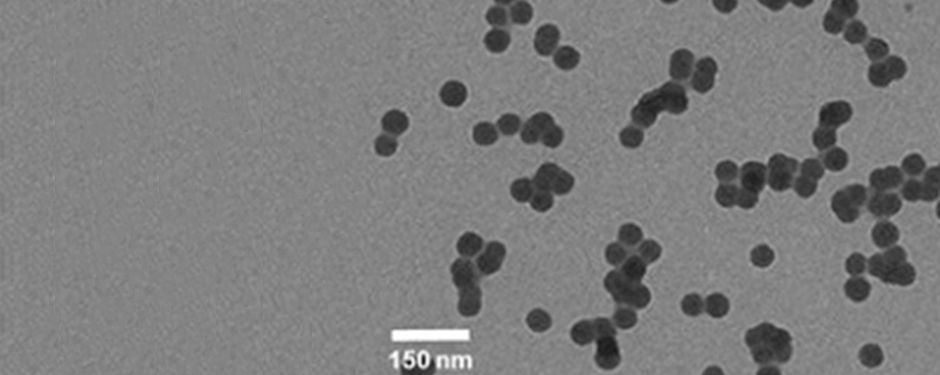
Blog-Knowledge-06-27-2017-Fine-tuning-CMP-slurries-for-3D-TSV-processes.jpg

-
All
-
Featured Solutions
-
Viewpoints
-
Knowledge
-
Industry Engagement
Featured Solutions

How DuPont Is Accelerating Optical Industry Innovation at its Taoyuan Site in Taiwan
In this video, Joyce Yeh, regional sales manager for silicones, discusses DuPont's enhanced and expanded Optical Silicone Lab in Taoyuan, Taiwan.

The materials science backbone of AI: Challenges and opportunities
Amid the breathless speculation about their mind-boggling possibilities, advanced computing and artificial intelligence applications face consequential but little-publicized performance hurdles.

The biggest threat to electric vehicles – and the materials solution
Thermal runaway is a critical safety issue in electric vehicles, occurring when a battery cell experiences an uncontrollable temperature increase. Flaws in or damage to a battery can spike heat within the battery.

Advancements in Thermal Management: Material Talk With Qnity
An insightful discussion featuring Mike Kwasny, business development manager at Qnity, delves into technologies and innovations in electronics manufacturing featuring their unique material solutions, including their Kapton® film and Pyralux® laminate lines.

Why Select DuPont™ Kapton® Films?
For more than five decades, DuPont has been at the forefront of material science, driving innovation and technological advancement with materials that have become synonymous with high-performance, reliability, and versatility.

Protecting Space Exploration Vehicles and Satellites
Protection of Rover’s sophisticated equipment is crucial to the overall success of the mission.

ESA Mission to Explore Jupiter’s Moons Features DuPont Technology
Kapton® protects Jupiter Icy Moons Explorer by providing thermal insulation against extreme temperatures encountered during the mission.

Helping Advance DuPont’s Sustainability Commitment: PCMPSolv™ Cleaning Solutions
DuPont PCMPSolv™ family performs advanced post-CMP cleaning with safer-by-design, green chemistries.

DuPont Pyralux® AP to Aid Reliable Performance of Semikron-Danfoss eMPack® Modules Powering Next-Gen Electric Vehicles
DuPont (NYSE:DD) Interconnect Solutions, part of the Qnity business, announced today a multiyear contract with European power module manufacturer Semikron-Danfoss

New digital hub features DuPont’s total solutions for advanced automotive interconnects
DuPont (NYSE:DD) Interconnect Solutions, part of the Qnity business, announced today a multiyear contract with European power module manufacturer Semikron-Danfoss who will integrate DuPont™ Pyralux® AP all-polyimide double-sided copper clad laminate into its eMPack® power modules to further enhance the capabilities of next-gen electric vehicles.

Kapton® Returns to the Moon
On November 16th, NASA successfully debuted its Space Launch System (SLS) rocket and the Orion capsule with a long-awaited launch from Kennedy Space Center, for what will be a more than month-long journey around the Moon.And as was the case for the first missions to the Moon, DuPont™ Kapton® polyimide films are onboard.

Fine-Line Patterning for SLPs Calls for High-Resolution Photoresist
Product miniaturization is driving demand for substrate-like PCBs (SLPs) with finer patterns, requiring advanced photoresist materials.

Thin Laminates as Embedded Capacitance for PDN Designs
Power distribution networks provide clean power for electronics. Using thin laminates for capacitance enables lighter end products with low signal noise

What drives a car that can drive itself? DuPont innovation.
On the autonomous road ahead, DuPont is helping catalyze a more sustainable world. With materials that vastly improve connectivity, reliability and processing speed.

Flexible laminates address flex circuits’ unique manufacturing challenges
Laminates designed for flexible substrates have numerous potential applications in consumer and industrial products

DuPont announces new product brand name - Duroptix® for LED silicone materials
Customers can continue to count on the same performance and durability of these high-performance silicone-based optical materials that they have come to trust.

Advanced polyimides for more flexible high-speed 5G networks
DuPont's Pyralux® AP with RA copper offer an ideal flexible circuit option in the race to 5G.

Low-Loss Materials Key for High-Frequency Applications
DuPont laminates meet low-loss requirements for 5G and other high-data-rate applications, including IoT and autonomous cars.
Viewpoints

Embedding flexibility in next-gen electronics design
Flexible printed circuit boards offer solutions for design engineers who face challenges fitting more components into smaller devices.

Meeting the horizontal electroless copper plating challenge
How DuPont addresses reliability demands and increased complexity of HDI and IC package substrates.

Press-fit solutions address future automotive reliability requirements
To meet reliability standards, automotive PCBs migrate to solderless press-fit interconnections.

Transitioning to chromium-free etch technology for plating on plastics
Dow reports on its progress with a plating on plastics process free from hexavalent chromium.

Nickel electroplating without boric acid
To comply with EU REACH legislation, boric acid replacement electrolytes for nickel are in development, with boric acid-free nickel plating already demonstrated.

Chromium-free etch technology for plating on plastic
How to eliminate hexavalent chromium when plating acrylonitrile butadiene styrene on plastic.

How silver catalysts enhance PCB manufacturing
Silver catalysts provide good catalytic activity, high electrical conductivity, modest cost, and good process stability, making PCB manufacturing a candidate for use

Autonomous cars driving next gen pcb material requirements
Why the automotive industry needs thermally stable PCB materials that withstand harsh environments.

Increasing smartphone functionality through novel metallization
Finer PCB Line/Space requirements are needed to deliver performance and DuPont has the solution.

Silver Plating technology driving 200°C automotive apps
How we overcame technical challenges to develop a flexible, high-performance automotive solution.

Miniaturization, Major Innovations Help Map the Course of Next-Gen PCBs
Innovation has no boundaries and consistently create miniaturized, extremely high-quality PCBs.

DuPont: Your Ultimate Flexible Circuit Materials Partner
Developing today’s complex high-tech electronic devices requires engineers to incorporate a range of materials with unique properties designed to help enable advanced functionality.
Knowledge

Examining unique TSV plating challenges
This tutorial examines the concept of copper through silicon via electroplating, which can increase reliability and decreases cost of subsequent process steps.
DuPont Solutions Are Enabling Next-Gen Automotive Electronics and Electrified Powertrain Component Innovations

Innovation in CMP: The Ikonic™ polishing pad platform
Colin Cameron discusses DuPont's biggest CMP portfolio expansion and its value in the marketplace.

Copper pillar electroplating tutorial
Learn about Cu pillar requirements and processing considerations for advanced chip packaging.

Cleaning up PCB final finish: cyanide-free ENIG coatings
Reliable, cyanide-free ENIG surfaces delivers low gold porosity and excellent corrosion resistance.

Copper electroplating fundamentals
This tutorial examines the concept of copper electroplating and how the process works, as well as its use in advanced packaging applications.

Managing fan-out wafer level packaging material properties, part 2
The key structures for FOWLP and considerations for managing material properties.

Fast, high-purity Cu plating enables next-gen devices
Copper plating forms critical connections from horizontal RDLs through vertical pillars.

Fan-out wafer-level packaging materials evolution
In the first of two parts, we examine the backstory of FOWLP and the markets it serves.

Fine-tuning CMP slurries for 3D TSV processes
DuPont's Michelle Ho explains the role of CMP in 3D TSV processes and discusses CMP slurry design.

Inkjet printing for eco-friendly PCB etch processes
Inkjet printing improves etch capability to meet tight tolerances, complex patterns and more.

Enhancing advanced PCB performance with corrosion-resistant electroless nickel
How to get excellent electrical and mechanical connections between advanced PCBs and IC packages.

Inner-layer Copper Reliability of Electroless Copper Processes
Understanding material interactions helps PCB manufacturing control and interconnect reliability.

New Kapton® Insulation Lasts Longer on High-Performance Traction Motor Conductors
Addresses the impact of higher switching frequency and faster voltage rise on motor insulation; shows eight-fold improvement over standard polyimide insulators.

Lithographic Material Evolution Continues to Enable the Semiconductor Industry
CD scaling, 3D structures and escalating costs drive advances in lithography and enabling materials

Innovative advancements in automotive infotainment require superior electronic devices
How do PCB engineers fit all the necessary inputs and outputs on their boards while also ensuring reliable, long-term operation in demanding environments?

DuPont Technology Protects Ingenuity Mars Drone Mission
Ingenuity took its maiden voyage over the Martian soil on April 19, 2021.

NASA’s Webb Telescope Keeping Cool with Ultra-thin DuPont™ Kapton® Polyimide Films
The excellent thermal and mechanical properties of Kapton® polyimide film make it an ideal material for space applications.

Kapton® Films and Pyralux® Laminates Provide Superior Performance in Satellite/Spacecraft Applications
DuPont offers space satellite applications product selection guide to assist in the development of the next generation of space vehicles.

Flexible Circuits Increase Range and Safety for Vehicle Batteries
Increased electrification of vehicles is a growing technology trend, driven in large part by advances in lithium (Li)-ion cells and battery pack design.
Industry Engagement
Featured Solutions

How DuPont Is Accelerating Optical Industry Innovation at its Taoyuan Site in Taiwan
In this video, Joyce Yeh, regional sales manager for silicones, discusses DuPont's enhanced and expanded Optical Silicone Lab in Taoyuan, Taiwan.

The materials science backbone of AI: Challenges and opportunities
Amid the breathless speculation about their mind-boggling possibilities, advanced computing and artificial intelligence applications face consequential but little-publicized performance hurdles.

The biggest threat to electric vehicles – and the materials solution
Thermal runaway is a critical safety issue in electric vehicles, occurring when a battery cell experiences an uncontrollable temperature increase. Flaws in or damage to a battery can spike heat within the battery.

Advancements in Thermal Management: Material Talk With Qnity
An insightful discussion featuring Mike Kwasny, business development manager at Qnity, delves into technologies and innovations in electronics manufacturing featuring their unique material solutions, including their Kapton® film and Pyralux® laminate lines.

Why Select DuPont™ Kapton® Films?
For more than five decades, DuPont has been at the forefront of material science, driving innovation and technological advancement with materials that have become synonymous with high-performance, reliability, and versatility.

Protecting Space Exploration Vehicles and Satellites
Protection of Rover’s sophisticated equipment is crucial to the overall success of the mission.

ESA Mission to Explore Jupiter’s Moons Features DuPont Technology
Kapton® protects Jupiter Icy Moons Explorer by providing thermal insulation against extreme temperatures encountered during the mission.

Helping Advance DuPont’s Sustainability Commitment: PCMPSolv™ Cleaning Solutions
DuPont PCMPSolv™ family performs advanced post-CMP cleaning with safer-by-design, green chemistries.

DuPont Pyralux® AP to Aid Reliable Performance of Semikron-Danfoss eMPack® Modules Powering Next-Gen Electric Vehicles
DuPont (NYSE:DD) Interconnect Solutions, part of the Qnity business, announced today a multiyear contract with European power module manufacturer Semikron-Danfoss

New digital hub features DuPont’s total solutions for advanced automotive interconnects
DuPont (NYSE:DD) Interconnect Solutions, part of the Qnity business, announced today a multiyear contract with European power module manufacturer Semikron-Danfoss who will integrate DuPont™ Pyralux® AP all-polyimide double-sided copper clad laminate into its eMPack® power modules to further enhance the capabilities of next-gen electric vehicles.

Kapton® Returns to the Moon
On November 16th, NASA successfully debuted its Space Launch System (SLS) rocket and the Orion capsule with a long-awaited launch from Kennedy Space Center, for what will be a more than month-long journey around the Moon.And as was the case for the first missions to the Moon, DuPont™ Kapton® polyimide films are onboard.

Fine-Line Patterning for SLPs Calls for High-Resolution Photoresist
Product miniaturization is driving demand for substrate-like PCBs (SLPs) with finer patterns, requiring advanced photoresist materials.

Thin Laminates as Embedded Capacitance for PDN Designs
Power distribution networks provide clean power for electronics. Using thin laminates for capacitance enables lighter end products with low signal noise

What drives a car that can drive itself? DuPont innovation.
On the autonomous road ahead, DuPont is helping catalyze a more sustainable world. With materials that vastly improve connectivity, reliability and processing speed.

Flexible laminates address flex circuits’ unique manufacturing challenges
Laminates designed for flexible substrates have numerous potential applications in consumer and industrial products

DuPont announces new product brand name - Duroptix® for LED silicone materials
Customers can continue to count on the same performance and durability of these high-performance silicone-based optical materials that they have come to trust.

Advanced polyimides for more flexible high-speed 5G networks
DuPont's Pyralux® AP with RA copper offer an ideal flexible circuit option in the race to 5G.

Low-Loss Materials Key for High-Frequency Applications
DuPont laminates meet low-loss requirements for 5G and other high-data-rate applications, including IoT and autonomous cars.
Viewpoints

Embedding flexibility in next-gen electronics design
Flexible printed circuit boards offer solutions for design engineers who face challenges fitting more components into smaller devices.

Meeting the horizontal electroless copper plating challenge
How DuPont addresses reliability demands and increased complexity of HDI and IC package substrates.

Press-fit solutions address future automotive reliability requirements
To meet reliability standards, automotive PCBs migrate to solderless press-fit interconnections.

Transitioning to chromium-free etch technology for plating on plastics
Dow reports on its progress with a plating on plastics process free from hexavalent chromium.

Nickel electroplating without boric acid
To comply with EU REACH legislation, boric acid replacement electrolytes for nickel are in development, with boric acid-free nickel plating already demonstrated.

Chromium-free etch technology for plating on plastic
How to eliminate hexavalent chromium when plating acrylonitrile butadiene styrene on plastic.

How silver catalysts enhance PCB manufacturing
Silver catalysts provide good catalytic activity, high electrical conductivity, modest cost, and good process stability, making PCB manufacturing a candidate for use

Autonomous cars driving next gen pcb material requirements
Why the automotive industry needs thermally stable PCB materials that withstand harsh environments.

Increasing smartphone functionality through novel metallization
Finer PCB Line/Space requirements are needed to deliver performance and DuPont has the solution.

Silver Plating technology driving 200°C automotive apps
How we overcame technical challenges to develop a flexible, high-performance automotive solution.

Miniaturization, Major Innovations Help Map the Course of Next-Gen PCBs
Innovation has no boundaries and consistently create miniaturized, extremely high-quality PCBs.

DuPont: Your Ultimate Flexible Circuit Materials Partner
Developing today’s complex high-tech electronic devices requires engineers to incorporate a range of materials with unique properties designed to help enable advanced functionality.
Knowledge

Examining unique TSV plating challenges
This tutorial examines the concept of copper through silicon via electroplating, which can increase reliability and decreases cost of subsequent process steps.
DuPont Solutions Are Enabling Next-Gen Automotive Electronics and Electrified Powertrain Component Innovations

Innovation in CMP: The Ikonic™ polishing pad platform
Colin Cameron discusses DuPont's biggest CMP portfolio expansion and its value in the marketplace.

Copper pillar electroplating tutorial
Learn about Cu pillar requirements and processing considerations for advanced chip packaging.

Cleaning up PCB final finish: cyanide-free ENIG coatings
Reliable, cyanide-free ENIG surfaces delivers low gold porosity and excellent corrosion resistance.

Copper electroplating fundamentals
This tutorial examines the concept of copper electroplating and how the process works, as well as its use in advanced packaging applications.

Managing fan-out wafer level packaging material properties, part 2
The key structures for FOWLP and considerations for managing material properties.

Fast, high-purity Cu plating enables next-gen devices
Copper plating forms critical connections from horizontal RDLs through vertical pillars.

Fan-out wafer-level packaging materials evolution
In the first of two parts, we examine the backstory of FOWLP and the markets it serves.
Fine-tuning CMP slurries for 3D TSV processes
DuPont's Michelle Ho explains the role of CMP in 3D TSV processes and discusses CMP slurry design.

Inkjet printing for eco-friendly PCB etch processes
Inkjet printing improves etch capability to meet tight tolerances, complex patterns and more.

Enhancing advanced PCB performance with corrosion-resistant electroless nickel
How to get excellent electrical and mechanical connections between advanced PCBs and IC packages.

Inner-layer Copper Reliability of Electroless Copper Processes
Understanding material interactions helps PCB manufacturing control and interconnect reliability.

New Kapton® Insulation Lasts Longer on High-Performance Traction Motor Conductors
Addresses the impact of higher switching frequency and faster voltage rise on motor insulation; shows eight-fold improvement over standard polyimide insulators.

Lithographic Material Evolution Continues to Enable the Semiconductor Industry
CD scaling, 3D structures and escalating costs drive advances in lithography and enabling materials

Innovative advancements in automotive infotainment require superior electronic devices
How do PCB engineers fit all the necessary inputs and outputs on their boards while also ensuring reliable, long-term operation in demanding environments?

DuPont Technology Protects Ingenuity Mars Drone Mission
Ingenuity took its maiden voyage over the Martian soil on April 19, 2021.

NASA’s Webb Telescope Keeping Cool with Ultra-thin DuPont™ Kapton® Polyimide Films
The excellent thermal and mechanical properties of Kapton® polyimide film make it an ideal material for space applications.

Kapton® Films and Pyralux® Laminates Provide Superior Performance in Satellite/Spacecraft Applications
DuPont offers space satellite applications product selection guide to assist in the development of the next generation of space vehicles.

Flexible Circuits Increase Range and Safety for Vehicle Batteries
Increased electrification of vehicles is a growing technology trend, driven in large part by advances in lithium (Li)-ion cells and battery pack design.
Industry Engagement

Join us at IMPACT Conference Taiwan 2025
Come and meet our experts in Qnity session "Shaping Our Future with AI by Next-Gen Substrate and Packaging" at IMPACT Conference Taiwan 2025. Qnity is proud to collaborate with industry leaders to explore advanced packaging and integrated circuit material solutions for artificial intelligence.

Thank you for joining us at SEMICON West 2025
Come and meet our experts at SEMICON Taiwan 2023 to discover our range of innovative solutions and experience our diverse and inclusive culture. We can't wait to see you there

DuPont and CAS Host Successful Webinar on the Advancements and Challenges of AR/VR Technologies
DuPont Display Technologies hosted a webinar with Chemical Abstracts Service (CAS), a division of the American Chemical Society, to discuss AR/VR technologies in July 2023.

ASMC Conference
Advanced Semiconductor Manufacturing Conference (ASMC)
May 5-8, 2025
Hilton Albany, New York

SPIE2025
SPIE Advanced Lithography & Patterning 2025
February 23 – 27
San Jose, California
Silicon valley technology center hub for collaboration
The Center fosters technology collaboration across DuPont businesses and partners in the Bay Area.

Join DuPont at IMPACT Conference Taiwan 2024
Come and meet our experts in DuPont session "Shaping Our Future with AI by Next-Gen Substrate and Packaging" at IMPACT Conference Taiwan 2024. DuPont is proud to collaborate with industry leaders to explore advanced packaging and integrated circuit material solutions for artificial intelligence.

SPIE2024
SPIE Advanced Lithography & Patterning 2024
February 25 – February 29
San Jose, California

Reddington Addresses Customers at IPC/APEX
In a presentation to customers at the DuPont booth during the Institute for Printed Circuits (IPC) APEX Exposition recently held in San Diego, CA, Erik Reddington said the company was committed to playing a role in returning printed circuit board manufacturing to the United States and Europe.

DuPont Interconnect Solutions Launches Virtual Expo
As you prepare to take on the next frontier of your industry, partner with DuPont. Let’s tackle tomorrow’s toughest challenges together.
We’re here to help.
We love to talk about how our electronics solutions can build business, commercialize products,
and solve the challenges of our time.